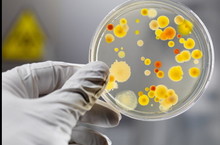

Муниципальное бюджетное дошкольное образовательное учреждение "Детский сад комбинированного вида №15 "Ромашка" Зеленодольского муниципального района Республики Татарстан" / Татарстан Республикасы Зеленодол муниципаль районы «Катнаш төрдәге № 15 «Ак чәчәк» балалар бакчасы» муниципаль мэктэпкэче белем бирү бюджет учреждениесе
Визитная карточка
| Адрес: | 422540, г. Зеленодольск, ул. Северная, д. 1 |
| Телефон: | +7(843)-715-13-38 |
| E-Mail: | Zel.15@tatar.ru, detsad15romashka@yandex.ru |
| Министерство: | Министерство образования и науки Республики Татарстан |
| Короткое название: | МБДОУ "Детский сад комбинированного вида №15 "Ромашка" ЗМР РТ" |
| Руководитель: | Будкина Ольга Александровна |
| Год основания учреждения: | 1974 |
| У нас учатся: | 174 ребенка |
| У нас учат: | 23 педагога |
Муниципальное бюджетное дошкольное образовательное учреждение "Детский сад комбинированного вида №15 "Ромашка" Зеленодольского муниципального района Республики Татарстан" / Татарстан Республикасы Зеленодол муниципаль районы «Катнаш төрдәге № 15 «Ак чәчәк» балалар бакчасы» муниципаль мэктэпкэче белем бирү бюджет учреждениесе - новости
Страницы: << 91 92 93 94 95 96 ( 97 ) 98 99 100 >>
-
ВСЕРОССИЙСКАЯ С МЕЖДУНАРОДНЫМ УЧАСТИЕМ НАУЧНО-ПРАКТИЧЕСКАЯ КОНФЕРЕНЦИЯ на тему: "Инновационные технологии и формы в комплексном сопровождении детей с отклонениями в развитии" 14.11.2013

-
Игра- суд "Мы за все на земле в ответе" 29.10.2013

-
Выставка поделок из природного материала " Лесное эхо" 28.10.2013

-
КВН "Красный,желтый,зеленый" 16.10.2013

-
Развлечение для малышей "Шалкан" 09.10.2013

-
День пожилого человека 01.10.2013

-
С днем знаний! 02.09.2013

День знаний, и, конечно же, День мира —
Таков для всех день первый в сентябре,
Когда под звуки вальса из эфира
Шлет поздравленья диктор детворе.
День знаний — мирный день, необходимый,
Как символ доброты и чистоты,
Давно и прочно горячо любимый,
И щедрый на улыбки и цветы. -
Парад колясок 31.08.2013

Наши милые и очаровательные мамочки со своими карапузами приняли активное участие в параде колясок, организованный на площади у музыкального театра в День города! Молодцы!
-
Видеонаблюдение в детском саду 23.07.2013

В нашем детском саду сегодня установлены и начали круглосуточную работу камеры видеонаблюдения. Система видеонаблюдения решает такие задачи, как наблюдение за территорией, за детскими площадками. При помощи камер наблюдения можно вести запись архива фактов различных происшествий, а также несанкционированного проникновения посторонних лиц, что очень важно в плане безопасного функционирования ДОУ.
-
Внимание - энтеровирусная инфекция! 12.07.2013